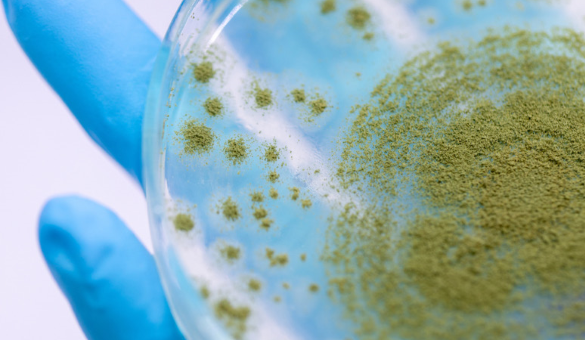

The ingredients in your cleaning products fall into several different categories, added to provide different characteristics and cleaning functions. Each product formula is a careful balance of various ingredients that will work best for what you are trying to clean.
For more information about the specific ingredients in a cleaning product, visit the manufacturer's website or look for the product in SmartLabel.
Surfactants

Surfactants provide most of the cleaning power in your cleaning products today, but other ingredients are also needed to make the best products possible. These ingredients help the surfactant work better on different types of soil. As we learned before, surfactants are the main force in cleaning and therefore make up a big portion of cleaning formulations.
It is also important to know that some surfactants are very good at removing some types of soils, but not very good at removing others. Many cleaning products include two or more surfactants in the formula. The choice of surfactants determines where the product will work best, such as for laundry, dishes, or counter-tops.
Builders

Builders are another important group of ingredients that help make cleaning products better. Builders give the surfactants a helping hand. They are found in a number of different kinds of products, but you need less of them than you do surfactants.
Builders help make the surfactant more powerful by reacting with minerals found in your home’s tap water (such as calcium and magnesium). The more minerals in your water, the “harder” the water is. It is not bad to have minerals in water, but it can leave white marks on surfaces (like dishes). When calcium and magnesium are present in water, they will stop surfactants from doing their job of removing soil.
Builders help prevent this by keeping the minerals out of the way of the surfactants. This leaves the surfactants alone to focus on the soil.
Solvents

Liquid cleaning products are solutions (chemicals dissolved in a liquid). Solvents are chemicals that help ingredients stay mixed and give cleaning products the right thickness so they are easy to use. In addition, organic solvents can help prevent liquid products from freezing in cold climates.
Without solvents, a product will be very thick. In some cases this might be a good thing (think of a bar of soap). But for other products, we want the liquid to pour out of the bottle. When we add solvents, we decrease the viscosity, meaning the liquid will move faster when poured out of the bottle. The solvent also helps to makes sure we do not end up with a separated solution—like when you have pulp at the bottom of your glass of orange juice.
Enzymes
Enzymes are powerful stain removing ingredients. Their power is to break down stains—just like the enzymes in our digestive system help break down the food we eat.
Enzymes are not living organisms but are created by microorganisms, like bacteria and fungi. In the laboratory, we use carefully selected microorganisms and allow them to grow in a very controlled environment. As they grow, they produce the desired enzymes.
In cleaning products, enzymes help to remove stains and help us to wash clothes in cold water.
Each enzyme is made up of amino acids placed like beads on a string. There can be anywhere between a hundred and a million amino acids for a single enzyme! The order of these amino acids determines the shape and function of the enzyme.
When added to a detergent formula, each enzyme will be attracted to a certain type of stain (like gravy or grass).
Once the enzyme finds a stain it likes, it gets to work breaking it down into smaller pieces and removing it from the surface we are trying to clean.
It is now easier for those smaller pieces to be picked up by the surfactant micelle.
And as we learned earlier, the micelle traps the stain particles—causing them to be washed away in the rinse water, leaving a clean surface.
For more information, visit our research study page and choose enzymes for the chemical class.
Fragrances
 Fragrances are a group of ingredients that provide the cleaning product with a pleasant smell. They are not found in every product, and typically a very small amount can make a large difference in smell. In many cases, the fragrance is the driving factor for why someone decided to buy a specific product.
Fragrances are a group of ingredients that provide the cleaning product with a pleasant smell. They are not found in every product, and typically a very small amount can make a large difference in smell. In many cases, the fragrance is the driving factor for why someone decided to buy a specific product.
A fragrance is a mix of many different substances. These ingredients may be natural compounds (that come from materials like flowers, fruit, trees, plants, or nuts), essential oils, or synthetic compounds. Lavender and lemon are two common fragrances that can be found in cleaning products.
One example of how a fragrance might be created is through a process called distillation, where the material is heated until it becomes a gas, and then the fragrant part is cooled down and condensed back into a liquid to be collected.
One type of fragrance technology is called encapsulation, which means fragrances are enclosed in a type of shell until caused to burst.

Fragrances create a pleasant smell when added to a cleaning product. They can also help cover up odors from any of the other ingredients in the formula.
When you wash clothes with a fragranced product, they not only get clean, but the pleasant smell is transferred onto your clothes!
Fragrance makes many people enjoy using the product. This fragrance may smell different in the bottle, in the wash, and on freshly washed clothing. The smell in wash is called the “bloom.”
So not only are your clothes clean, but they smell great too!
Fragrances can also be designed to stay on clothes, which allows clothes to smell cleaner and fresher for a long period of time.
Preservatives
 Just like it is important to prevent food from spoiling, cleaning products need to be preserved as well. Adding a small amount of a preservative protects the product from microorganisms.
Just like it is important to prevent food from spoiling, cleaning products need to be preserved as well. Adding a small amount of a preservative protects the product from microorganisms.
A preservative is a substance added to a cleaning product in order to make it stable and safe for a longer period of time. Without a preservative, it is possible for bacteria or fungi to grow in the product. This can cause the ingredients in the product (like surfactants and enzymes) to break down and not work as well. Adding a preservative allows a cleaning product to stay on the shelf longer, both in the store and in your home.
pH Adjusters
Every cleaning product needs to be “balanced” to work well and to be safe for your skin. In order to do this, chemists use pH adjusters to make sure the product is balanced and safe for you to use. The amount used depends on the other ingredients in the formula.
 What is pH? pH is how we measure if a solution is acidic (like lemon juice) or basic (like baking soda). The pH scale is read from 0 to 14, and tells us if a solution is acidic or basic. Pure water has a pH of 7, which means it’s neutral.
What is pH? pH is how we measure if a solution is acidic (like lemon juice) or basic (like baking soda). The pH scale is read from 0 to 14, and tells us if a solution is acidic or basic. Pure water has a pH of 7, which means it’s neutral.
pH adjusters are used in cleaning products to raise or lower the pH of a solution, making it either more basic or acidic.
Chemists make sure that the product is effective while balancing safety, in part, by making sure the pH will not be harmful if it touches your skin.
If the pH is less than 7, then the solution is acidic. Lemon juice has a pH around 2. Our skin is slightly acidic, with a pH on average near 5. If our skin comes into contact with a chemical that is too acid it can cause itching or discomfort.
If the pH is greater than 7, then the solution is basic. For example, baking soda has a pH of around 9. If a solution is too alkaline (basic), it can also irritate your skin.
Adjusting the pH helps to keep the product working well. It also affects how the product cleans. For example, each surfactant has a different pH range in which they are the most powerful. Therefore, a chemist may want to adjust the pH to that level
Antibacterial or Disinfecting Ingredients

Cleaning washes away germs with any dirt and soil that is removed, but a further reduction of germs can be achieved by using additional ingredients that will actually kill germs.
Antibacterial or disinfecting ingredients can be included in a cleaning or hand hygiene product, or used separately after cleaning. Their use provides a further reduction in germs on our hands or surfaces in our homes. This reduction of germs helps to prevent people from getting sick when commonly used surfaces, such as door handles or our hands, are cleansed using these products. In environments with sick individuals or where food is prepared, this is especially important.
There are many different types of antibacterial or disinfecting ingredients. Depending on the chosen ingredient used in a product, it may be more effective on certain microbes that make us sick like bacteria, viruses or mold.
Learn about the research ACI is doing focused on the area of topical antiseptics.
Microbes
There are microorganisms (also called microbes) everywhere you look. They are generally benign or even beneficial to humans and most won’t make you sick. They live in large numbers on virtually everything. Microbial-based cleaners are cleaning products which use these microorganisms as an ingredient to enhance cleaning or odor neutralizing performance. Bacillus spores are the most commonly used “friendly” microorganisms.
Microbial-based cleaning products usually have many of the ingredients found in other cleaning products, which perform the initial function of removing dirt and stains. Once the initial soil is removed, then the microbes get to work, settling into the nooks and crannies of a surface. When they come in contact with moisture and a food source, they will eventually begin to grow and produce enzymes that will break down soils. What we perceive as soil, the bacteria perceive as food. While the change may not be immediately noticeable to the human eye, comparing a surface over a period of several days or weeks typically shows the removal of residual soil.
One thing to keep in mind is that the use of disinfecting products may interfere with the microbial-based cleaner by inhibiting the growth of the microbes.

Additional Ingredients
Dyes
Dyes are sometime used to give a product a color. This can make a product more appealing to a shopper at the store.
 Thickeners
Thickeners
Thickeners give soap the prop er viscosity (thickness), making sure it can flow out of a bottle slowly enough to avoid spills. Can you imagine trying to wash your hands with a soap that feels like water? It would run right off of your skin!
Foam Enhancers
Foam Enhancers help create suds or bubbles. While not necessary for effective cleaning, many people feel bubbles show that a product is working.
Learn More About the Science of Cleaning at ExplorationClean.org